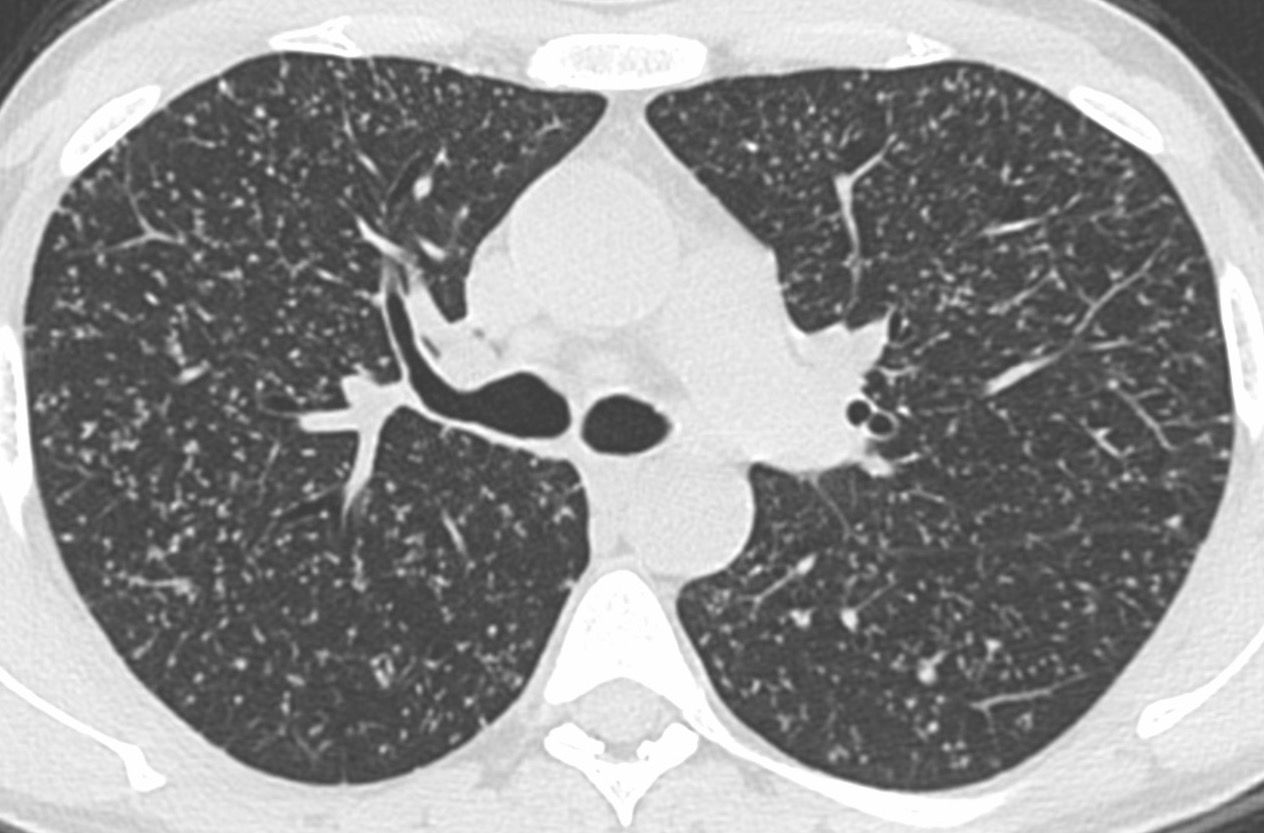

Case 84: Same Sized Small Lung Nodules
30-years old with cough and fever
This is a 30-years old who presented with cough and fever.
The chest radiograph showed this pattern.
What do you think the diagnosis is?
- Miliary TB
- Metastases
- Tree-in-bud - infectious bronchiolitis TB
- Tropical eosinophilia

Following this chart allows us to make the diagnosis. You can access the lecture here.
Approach to Small Diffuse Lung Nodules - Lecture
A flow-chart for small diffuse lung nodules

This post is for paying subscribers only
SubscribeAlready have an account? Log in





